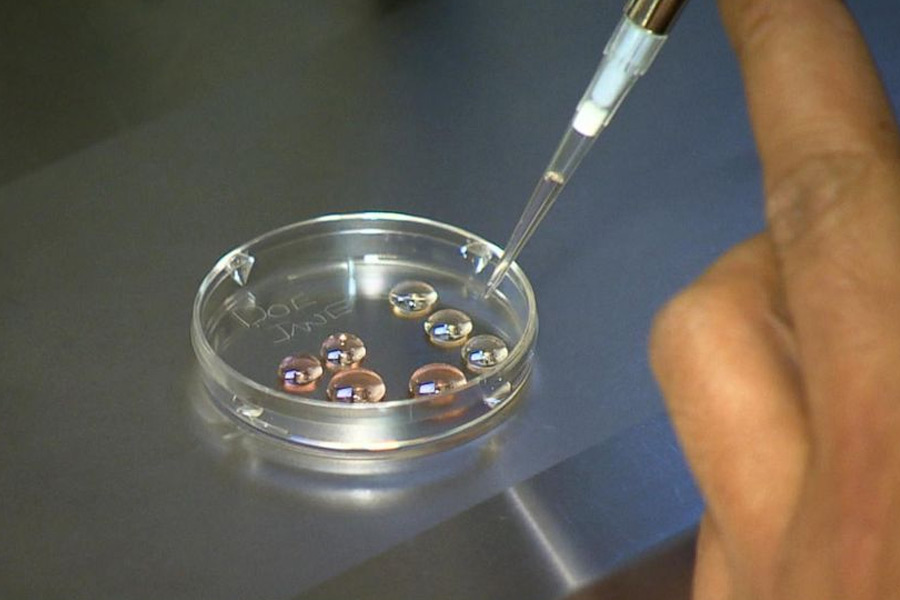
Why thousands of Taiwanese women are freezing eggs

বিয়ের আগে ডিম্বাণু সংরক্ষণ করছেন তাইওয়ানের হাজারো মহিলা! কারণ কী?
স্বশাসিত দ্বীপরাষ্ট্র তাইওয়ানে মহিলা প্রতি জন্ম দেওয়ার হার ০.৮৯ শতাংশ, যা বেশ কম। তাইওয়ানের পাশাপাশি দক্ষিণ কোরিয়া এবং হংকংয়ের মহিলাদের মধ্যেও জন্ম দেওয়ার হার কম।


তাইওয়ানের হাজার হাজার মহিলার মধ্যে বৃদ্ধি পাচ্ছে ডিম্বাণু হিমায়িত করার প্রবণতা। পরবর্তী সময়ে সন্তান ধারণ করতে যাতে কোনও অসুবিধা না হয়, সেই কারণে এই বিকল্প পথে হাঁটছেন তাইওয়ানের বহু মহিলা। যদিও অবিবাহিত মহিলাদের বিয়ে না করে ডিম্বাণু ব্যবহারের অনুমতি দেয় না সে দেশের সরকার।


কী বলছে সেই আইন? তাইওয়ানের বর্তমান আইন অনুযায়ী, সে দেশের কোনও অবিবাহিত মহিলা চাইলে ডিম্বাণু সংরক্ষণ করতে পারবেন। কিন্তু কোনও পুরুষকে বিয়ে না করা পর্যন্ত তাঁরা সেই ডিম্বাণু ব্যবহার করতে পারবেন না।


স্বশাসিত দ্বীপরাষ্ট্র তাইওয়ানে মহিলা প্রতি জন্ম দেওয়ার হার বেশ কম, ০.৮৯ শতাংশ। তাইওয়ানের পাশাপাশি দক্ষিণ কোরিয়া এবং হংকংয়ের মহিলাদের মধ্যেও সন্তান জন্ম দেওয়ার হারও কম।


তাইওয়ানের অবিবাহিত মহিলারা তাঁদের ডিম্বাণু হিমায়িত করতে পারেন। তবে কোনও পুরুষকে বিবাহের পর সেই ডিম্বাণু ব্যবহার করা যেতে পারে। অবিবাহিত মহিলা এবং সমকামী দম্পতিদের সেই ডিম্বাণু ব্যবহার করে মা হওয়ার অনুমতি দেয় না তাইওয়ান সরকার। তাইওয়ানের প্রতিবেশী চিনে অবিবাহিত মহিলাদের ডিম্বাণু হিমায়িত করে রাখার অধিকারও নেয়।


তাইওয়ানের চিকিৎসকদের একাংশ জানাচ্ছেন, আমেরিকার প্রায় ৩৮ শতাংশ মহিলা ভবিষ্যতের কথা মাথায় রেখে নিজেদের ডিম্বাণু সংরক্ষিত রাখেন। কিন্তু কড়া আইনের কারণে তাইওয়ানে এই সংখ্যা আট শতাংশের কাছাকাছি।
আরও পড়ুন:


তাইওয়ানের ৩৩ বছর বয়সি ভিভিয়ান তুং অবিবাহিত হওয়া সত্ত্বেও নিজের ডিম্বাণু হিমায়িত করে রাখার সিদ্ধান্ত নিয়েছেন।


প্রতি দিন পেটে একটি করে বিশেষ ইঞ্জেকশন নিতে হয় ভিভিয়ানকে। ইঞ্জেকশনের মাধ্যমে নেওয়া সেই হরমোন ডিম্বাণু উৎপাদনকে আরও সক্রিয় করে তোলে।


ডিম হিমায়িত করার জন্য ৩৩ বছর বয়সি ভিভিয়ানকে দুই সপ্তাহ ধরে প্রতি দিন এই ইঞ্জেকশন নেওয়ার পরামর্শ দিয়েছেন চিকিৎসকেরা।


ভিভিয়ানের কথায়, ‘‘এটা অনেকটা বিমা করার মতো।’’ তিনি জানিয়েছেন, তাইওয়ানের বহু মহিলা স্বাধীন এবং চাকুরিজীবী। শুধুমাত্র সন্তান ধারণের জন্য বিয়ে করতে তাঁরা চান না৷ আর সেই কারণে ভবিষ্যতের কথা ভেবে ডিম্বাণু জমিয়ে রাখার দিকে ঝোঁক বাড়ছে তাইওয়ানের বহু মহিলার।
আরও পড়ুন:


ভিভিয়ান বলেন, ‘‘আমার পরিবার আমায় সমর্থন করে এবং আমার ইচ্ছা-অনিচ্ছার দাম দেয়। তাই আমার সিদ্ধান্তে তারা কখনও বাধা হয়ে দাঁড়ায়নি।’’


ভিভিয়ান জানিয়েছেন, ডিম্বাণু হিমায়িত করার জন্য তাঁকে অস্ত্রোপচারের আগের দু’সপ্তাহ নিয়মিত চিকিৎসাকেন্দ্রে গিয়ে শারীরিক পরীক্ষা করাতে হয়।


ভিভিয়ান আশাবাদী যে, ভবিষ্যতে অবিবাহিত মহিলাদেরও সন্তান ধারণের অনুমতি দিতে পারে তাইওয়ান সরকার। আর সেই কারণেও আগেভাগে নিজের ডিম্বাণু সংরক্ষণ করে রাখছেন তিনি।


২০১৯ সালে এশিয়ার প্রথম দেশ হিসাবে সমকামী বিবাহকে বৈধতা দেয় তাইওয়ানের আইন। সমকামী দম্পতিদের সন্তান দত্তক নেওয়ার অধিকারও দেওয়া হয়েছে। আর সেই কারণেই ভাল কিছু হওয়ার আশায় বুক বাঁধছেন ভিভিয়ানের মতো হাজারো মহিলা।


তাইওয়ানে মাত্র চার শতাংশ দম্পতির পরিবারে প্রাকৃতিক ভাবে শিশুর জন্ম হয়। আমেরিকায় সেই সংখ্যা ৪০ শতাংশের কাছাকাছি।


তাইপেইয়ের ‘শিন কং উ হো-সু মেমোরিয়াল’ হাসপাতালের প্রজনন চিকিৎসাকেন্দ্রের প্রধান লি ই-পিং জানিয়েছেন, সরকারের সঙ্গে বেশ কয়েকটি সংস্থা প্রতিনিয়ত আলোচনা করে চলেছে। হিমায়িত ডিম্বাণুর সাহায্যে সন্তান জন্ম দেওয়ার ব্যাপারে সরকার যেন আইনে পরিবর্তন আনে, তা নিশ্চিত করার জন্যই এই আলোচনা।


‘ন্যাশনাল তাইওয়ান ইউনিভার্সিটি’ হাসপাতালের একটি সমীক্ষা অনুযায়ী, তাইওয়ানে ডিম্বাণু হিমায়িত করার চাহিদা বেড়েছে। গত তিন বছরে ৩৫ থেকে ৩৯ বছর বয়সি মহিলাদের মধ্যে এই প্রবণতা ৮৬ শতাংশ বেড়ে গিয়েছে।


তাইওয়ানের প্রথম ডিম্বাণু ব্যাঙ্ক, ‘স্টর্ক ফার্টিলিটি ক্লিনিক’-এর প্রতিষ্ঠাতা চিকিৎসক লাই হসিং-হুয়ার কথায় করোনা অতিমারির পর থেকে ডিম্বাণু সংরক্ষণ করার প্রবণতা মহিলাদের মধ্যে বেড়েছে। সঠিক পরিষেবা দিতে সেই সংস্থার তরফে এক ডজনেরও বেশি নতুন কেন্দ্র খোলা হয়েছে।

লাই জানিয়েছেন, তাইপেই এবং সিঞ্চুতে ডিম্বাণু সংরক্ষণ করে রাখা মহিলাদের সংখ্যা ৫০ শতাংশ বেড়েছে।


তবে তাওইওয়ানের চিকিৎসকরা জানাচ্ছেন, ডিম্বাণু সংরক্ষণ করে রাখার খরচের জন্য অনেক মহিলা এখনও সেই পথে এগোচ্ছেন না।


সংবাদমাধ্যমের প্রতিবেদন অনুযায়ী, ডিম্বাণু সংরক্ষণের প্রথম ধাপেই প্রায় ৪০-৫০ হাজার টাকা খরচ হয়ে যায়। এর পর সারা বছর তা জমিয়ে রাখার খরচ বাবদ আরও অনেক টাকা ব্যয় হয়।







